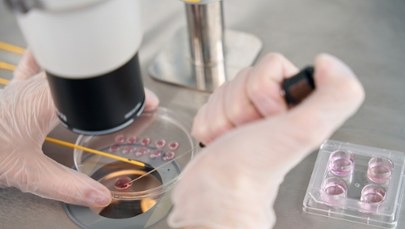
Dzieci na zamówienie? Rodzice płacą fortunę za "inteligentne" embriony

Trzy osoby zginęły, a osiem zostało rannych - to efekt strzelaniny w klubie w Nowym Jorku. Doszło do niej w niedzielę nad ranem - przekazała lokalna policja, cytowana przez agencję Associated Press. Paradoksalnie, w 2025 r. w Nowym Jorku odnotowano dotychczas rekordowo małą liczbę aktów przemocy z użyciem broni palnej.
Sprawcy otworzyli ogień z kilku sztuk broni w klubie Taste of the City Lounge w Crown Heights na Brooklynie. Strzelaninę poprzedziła kłótnia.
Do zdarzenia doszło tuż przed godz. 3.30 nad ranem czasu lokalnego (godz. 9.30 czasu polskiego). W wyniku zdarzenia zginęło trzech mężczyzn - przekazała Jessica Tisch, komisarz Departamentu Policji Nowego Jorku.
Ofiary śmiertelne to osoby w wieku 27 i 35 lat, a także trzecia osoba, której wiek nie został jeszcze określony - podała telewizja NBC.
To straszna strzelanina - powiedziała Jessica Tisch na konferencji prasowej.